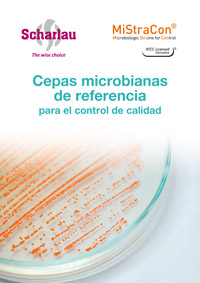
Cepas Mistracon control calidad

Control de los medios de cultivo con cepas MiStraCon®
27 de octubre de 2023Las cepas MiStraCon® Scharlau de la American Type Culture Collection (ATCC®) incluyen las cepas más comúnmente utilizadas en la industria alimentaria, la industria farmacéutica, el control de la calidad del agua y en entornos clínicos.
Scharlab está adjunta al programa de derivados con licencia de ATCC®. Así, la marca ATCC Licensed Derivative establece que Scharlab S.L. tiene licencia para utilizar estas marcas comerciales y vender productos derivados de cultivos ATCC®.
Todos los productos MiStraCon® se suministran con instrucciones detalladas de uso y cuentan con un certificado de análisis que garantiza su autenticidad, trazabilidad y el número de subcultivos elaborados a partir del cultivo de referencia original.

Cepas MiStraCon® Scharlau: tres formatos de productos
Esta línea de productos Scharlau consta de tres formatos de productos:
MiStraCon®Swabs2
Cepas bacterianas no cuantificadas en pellet liofilizado preparado para autohidratarse y para ser utilizado directamente mediante un hisopo incorporado en el dispositivo.
MiStraCon®QuantyPellets
Cepas bacterianas cuantificadas en pellet liofilizado listo para hidratar y usar en ensayos de promoción de crecimiento de medios de cultivo. Uso habitual en industria farmacéutica.
MiStraCon®QuantyE-Pellets
Cepas bacterianas cuantificadas presentadas en pellet liofilizado listo para hidratar y preparar diluciones cuantificadas.
Formato MiStraCon®Swabs2
| Formato | Embalaje | Contenido | UFC | Aplicaciones/Especificaciones |
| MiStraCon®Swabs2 | Cada unidad contiene un pellet liofilizado y fluido hidratante Un hisopo para la inoculación, todo sellado en un sobre aluminizado | 2 unidades de MiStraCon®Swabs2 | No cuantificado | Cultivos. Control de calidad diario. Control de calidad de los sistemas de identificación y kits de ensayo. Control de calidad de la prueba de susceptibilidad antimicrobiana. Verificación y validación. |
Formatos MiStraCon®QuantyPellets y MiStraCon®QuantyE-Pellets
| Formato | Embalaje | Contenido | UFC | Aplicaciones/Especificaciones |
MiStraCon®QuantyPellets | 1 caja. Cada caja contiene 5 viales de un solo microorganismo cuantificado y 5 viales de fluido hidratante | 5 viales con 1 pellet cuantificado (1 pellet / vial) y 5 viales de fluido hidratante (1,2 mL) | <100 por 0,1 mL cuando se procesa de acuerdo a las instrucciones | Pruebas de promoción de crecimiento. Prueba de desafío de medios. Idoneidad de los métodos de conteo. Idoneidad de las pruebas de esterilidad. Idoneidad de las pruebas para microorganismos especificados. Pruebas de límites microbianos. Pruebas de enumeración microbiana. Validación de los métodos de neutralización. Métodos que requieren una baja concentración de UFC. |
MiStraCon®QuantyE-Pellets | 1 vial con pellets liofilizados en una bolsa de plástico con sello hermético | 1 vial con 5 pellets | 1,0E+03 – 1,0E+07 por pellet | Métodos de detección y enumeración. Verificación / Validación. Determinación de carga biológica. Concentración letal mínima. Cualificación desinfectante. Pruebas de agua. Pruebas de aptitud. Métodos que requieren un rango específico de UFC. |
Tanto para ampliar estas informaciones como para solicitar otros productos o servicios escribe a consultas@scharlab.com.

 Resto del Mundo
Resto del Mundo